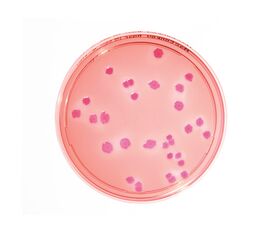

説明
【特徴】
●日本薬局方適合の生培地です。
【仕様】
●型番:1.46022.0020
●培地名:マッコンキーアガー
●適用:大腸菌
●保存温度:15~25℃
●有効期限:6ヶ月
●入数:1箱(30mL×20枚入)
●JP/USP/EP適合
追加情報
メーカー名:
Merck
メーカー品番:
1.46022.0020
予定納期:
通常1週間-10日で発送予定